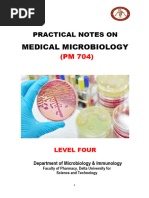

Staphylococcus Vs. Streptococcus.
A Comprehensive Analysis. Comparison and
Contrast.
I. Mutual Characteristics: Both genera are Gram positive and have the
similar spherical cell shape, therefore there are called cocci (in Greek coccus
means granule).
II. Visual differentiation between Staphylococci and
Streptococci by cellular arrangement:
When performing laboratory analysis, after Gram staining, first thing we
should do is put a piece of a colony under microscope and observe cellular
arrangement of the bacteria. Both staphylococci and streptococci have round,
spherical cell shape, but the arrangement of cells is different due to a
different binary fission. Streptococci form a chain of round cells, because
their division occurs in one linear direction, whereas staphylococci divide in
various directions forming grape-like clusters.
III. Biochemical differentiation between Staphylococci and
Streptococci with CATALASE test:
The main criterion for differentiation between Staphylococcus and
Streptococcus genera is the catalase test. Staphylococci are catalase positive
whereas Streptococci are Catalase negative. Catalase is an enzyme used by
bacteria to induce the reaction of reduction of hydrogen peroxide into water
and oxygen.
III-A. Biochemical differentiation among Staphylococci:
�There are at least three Staphylococci species of clinical importance:
1. Staphylococcus aureus is the most pathogenic for humans
2. Staphylococcus epidermidis, which is part of the normal flora and is of low
pathogenicity, and
3. Staphylococcus saprophyticus which can cause urinary tract infections,
especially in sexually active young women.
1.Differentiation between Staphylococcus aureus and other Staphylococci:
- COAGULASE test which is positive for Staphylococcus aureus (generally
accepted criterion for the identification) and negative for all other
Staphylococci. Coagulase is an enzyme used by S.aureus to induce
coagulation and convert soluble fibrinogen into fibrin which will protect
bacteria from the immune system. It is also a clumping factor for bacterias
coalescence. All other staphylococcus species can be collectively referred to
as coagulase-negative staphylococci.
- STAPHYLOSLIDE test that will determine if bacteria has two types of
proteins: Fibrinogen receptor and Protein A. With this test S. aureus will
cause notable agglutination. Agglutination will not be seen if the isolate is S.
epidermidis or S. saprophyticus.
- Presence of HEMOLYSIS. While others dont have any, Staphylococcus
aureus has Beta hemolysis. 2.Differentiation between Staphylococcus
epidermis and Staphylococcus saprophyticus can be made with reaction to
NOVOBIOCIN (antibiotic produced by the actinomycete Streptomyces
nivens and used to treat infections by gram-positive bacteria). S.
saprophyticus is resistant to novobiocin (at a concentration of 5 mg), and this
is used to differentiate the organism from S. epidermidis which is susceptible
to novobiocin.
Catalase test
Coagulase test
Staphyloslide
test
Colour
differences in
colonies
Hemolysis test
Reaction to
Novobiocin
Staphylococcus
aureus
Staphylococcu
s epidermidis
+
+
+
+
-
Staphylococc
us
saprophyticu
s
+
-
Gold yellow
White
White to yellow
Beta
Sensitive
None
Sensitive
None
Resistant
�III-B. Biochemical differentiation among Streptococci:
The various streptococci have genus-species Latin names. However,
traditionally, clinical laboratories report them by their type of
hemolysis and Lancefield serological group. The first step in correctly
identifying a Streptococcus in the clinical laboratory is an accurate
determination of the type of hemolysis the organism produces. Streptococci
may be classified into two main divisions on the basis of their hemolytic action
on blood agar:
I. Beta hemolyticcomplete hemolysis of erythrocytes
These are arranged into 18 groups A-U known as Lancefield groups. Groups
are determined by PRECIPITIN test, serologic test to measure a specific
reaction between antigen (C carbohydrate, located in the cell wall) and
antibody which results in a visible precipitate.
Group A Streptococci (Streptococcus pyogenes) is among the most important
human pathogens. Their important diagnostic criterion is susceptibility
to Bacitracin (polypeptide antibiotic obtained from a strain of the
bacterium Bacillus subtilis and used as a topical treatment for certain
bacterial infections, especially those caused by cocci). Many strains have a
hyaluronic acid capsule that is antiphagocytic. Group BStreptococci
(Streptococcus agalactiae) are bacitracin resistant.
Group D include Enterococci (Streptococcus faecalis) and Non-enterococci
(Streptococcus bovis). Enterococci grow in 6.5% NaCl and are not killed by
penicillin G (the most commonly used penicillin compound, used primarily in
the form of its stable salts, also called benzylpenicillin). Non-enterococci are
inhibited by 6.5% NaCl and killed by Penicillin G.
II. Non-Beta Hemolytic (Alpha hemolyticpartial or green hemolysis of
erythrocytes or Gamma hemolyticno hemolysis.). Differentiation among
this group can be made with OPTOCHIN test. Members of this group are:
Streptococcus pneumoniae: Inhibited by Optochin (ethyl hydrocupreine).
Viridans group of Streptococci (Streptococcus mitis, Streptococcus sanguis
and Streptococcus mutans): not inhibited by optochin and not bile-soluble, in
contrast to S.pneumoniae. Streptococcus mutans synthesizes polysaccharides
(dextrans) that are found in dental plaque and lead to dental caries
S. pyogenes
S. agalactiae
Lancefield
group
Hemolysis
Diagnostic
features
A
B
Beta
Beta
Bacitracin sensitive
Bacitracin resistant
Hippurate
hydrolyzed
�S. faecalis
(Enterococcus)
S. bovis
D
D
Alpha or Beta or
none
Alpha or none
S. pneumoniae
Not applicable
Alpha
Viridans group
Not applicable
Alpha
Growth in 6.5%
NaCl
No Growth in 6.5%
NaCl
Bile soluble
Inhibited by
optochin
Not bile soluble
Not inhibited by
optochin
Significance of Catalase test in Microbiology
All aerobes and facultative anaerobe microorganisms use oxygen for growth
and metabolism. The superoxide anion is a product of oxygen reduction and is
capable of participating in destructive reactions potentially lethal to the cell.
Moreover, products of secondary reactions may amplify toxicity.
For example, one hypothesis holds that the superoxide anion reacts with
hydrogen peroxide in the cell:
O2 + H2O2 ' OH + OH. + O2
This reaction, known as the Haber-Weiss reaction, generates a free hydroxyl
radical (OH.), which is the most potent biologic oxidant known. It can attack
virtually any organic substance in the cell. Aerobe and facultative anaerobe
microorganisms contain a high concentration of an enzyme called superoxide
dismutase. This enzyme converts the superoxide anion into ground-state
oxygen and hydrogen peroxide, thus freeing the cell of destructive superoxide
anions:
2O2 + 2H+ Superoxide Dismutase O2 + H2 O2
The hydrogen peroxide generated in this reaction is an oxidizing agent, but it
does not damage the cell as much as the superoxide anion and tends to
diffuse out of the cell. Many organisms possess catalase or peroxidase or
both to eliminate the H2O2. Catalase is enzyme that decomposes hydrogen
peroxide (H2O2) to water and ground-state oxygen
H2O2 + H2O2 Catalase 2H2O + O2
Catalase test is particularly useful in differentiating staphylococci genus and
family of micrococcacae (genera: Arthrobacter and Micrococcus) , which are
catalase-positive, from streptococci and enterococci, which are catalasenegative.
How to perform the test? - Dip a capillary tube into 3%H2O2. .Touch a
colony .Observe the tube for bubble indicating a positive reaction. Result:
Bubles: positive, no bubbles: negative reaction.
�Special Features - catalase is found in most aerobic and facultative
anaerobic bacteria. The main exception is Streptococci, which have catalase
negative test. Catalase is not found in anaerobes.
Precautions in interpretation: It is important not to contaminate the
bacterial colony under test with blood agar. Red blood cells contain catalase
and their presence will give a false positive result. Old cultures may loose
their catalase activity, possible resulting in a false negative result.
Microorganism
Staphylococci
Streptococci
Actinomyces israelii
Fusobacterium
Prevotella melaninogenica
Family of Enterobacteriaceae
- Escherichia colli
- Salmonella
- Shigella
Clostridium
Catalase test
Positive (exception: Staphylococcus
aureus, subspecies anaerobius is
catalase negative)
Negative
Negative
Negative
Negative
Positive
Rare types from moderate to mostly
non-reactive
Moderate positive reaction
Mostly non-reactive
Negative
As stated in Catalase Test as an Aid to the Identification of
Enterobacteriaceae research paper published in 1972, family of
enterobacteriaceae have differentiation of catalase positive reaction, from
vigorous ( Serratia, Proteus and Providencia), moderate ( Salmonella, some
rare types of Escherichia, Enterobacter and Klebsiela) to non-reactive (most
types of Escherichia and Shigella).